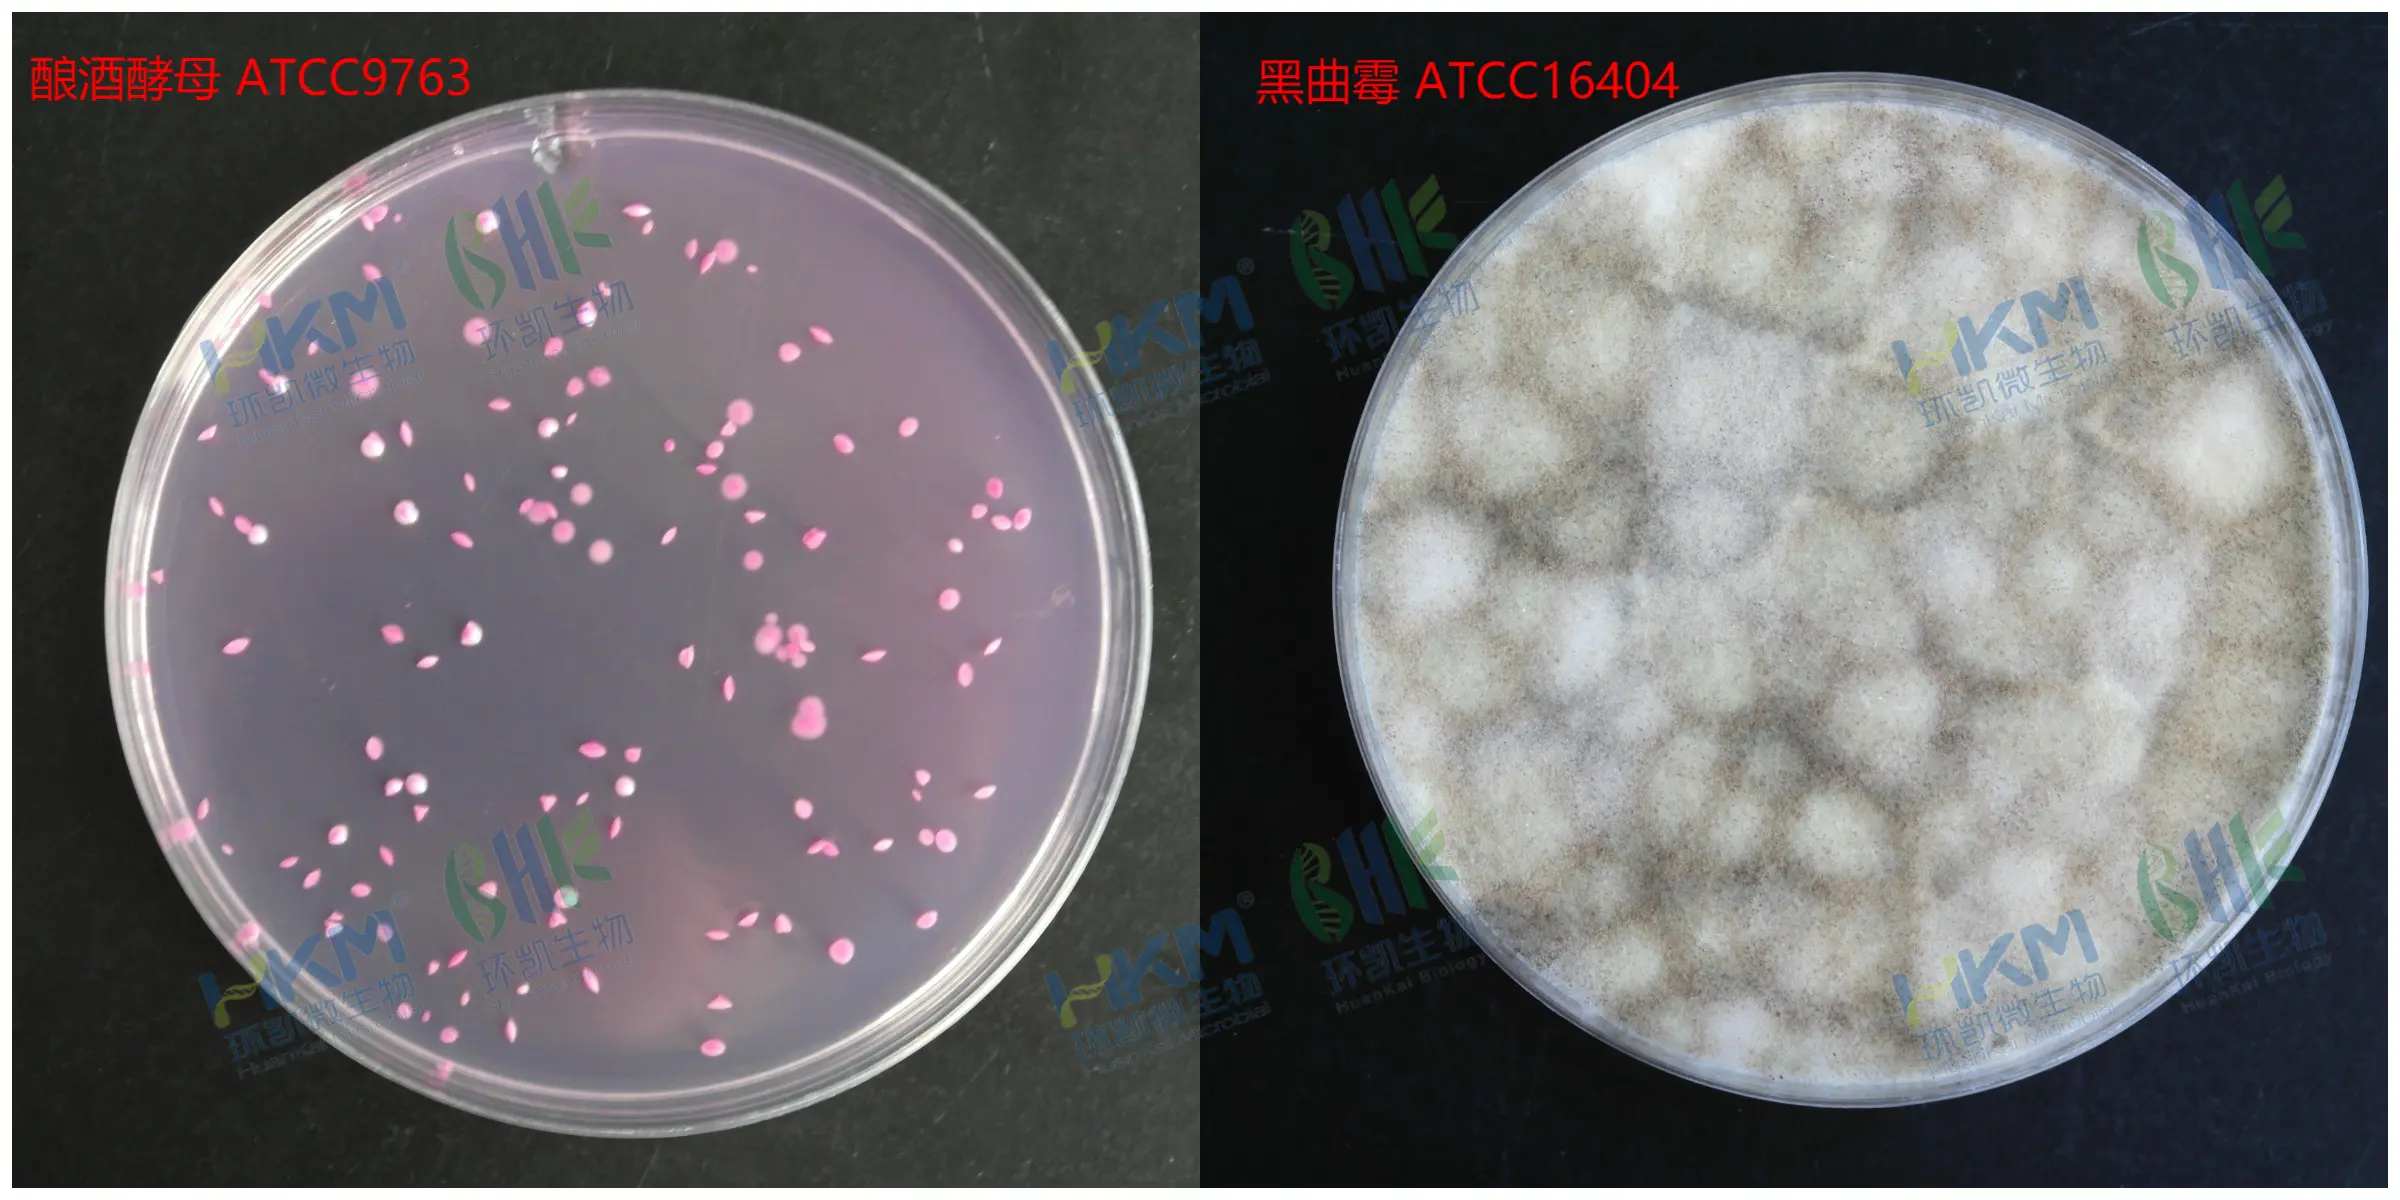
不同质控菌株接种于孟加拉红(虎红)琼脂培养基的菌落特征反应图

| 序号 | 021010 | ||||||||||||||||||||||||||||||||||||||||||||||||||||||||||||||||||||||||||||||||||||||||||||||||||||||||||||||||||||||||||||||||||||
| 中文名 | 孟加拉红(虎红)琼脂培养基配方 021010 | ||||||||||||||||||||||||||||||||||||||||||||||||||||||||||||||||||||||||||||||||||||||||||||||||||||||||||||||||||||||||||||||||||||
| 英文名 | Rose Bengal Agar | ||||||||||||||||||||||||||||||||||||||||||||||||||||||||||||||||||||||||||||||||||||||||||||||||||||||||||||||||||||||||||||||||||||
| 用途 | 孟加拉红(虎红)琼脂供霉菌和酵母的计数、分离和培养用(GB4789.15,化妆品卫生规范)。 | ||||||||||||||||||||||||||||||||||||||||||||||||||||||||||||||||||||||||||||||||||||||||||||||||||||||||||||||||||||||||||||||||||||
| 标准 | GB 4789.15、化妆品卫生规范 | ||||||||||||||||||||||||||||||||||||||||||||||||||||||||||||||||||||||||||||||||||||||||||||||||||||||||||||||||||||||||||||||||||||
| 配方(g/L) | 蛋白胨 5g 葡萄糖 10g 磷酸二氢钾 1g 硫酸镁 0.5g 琼脂 15g 孟加拉红 0.033g 氯霉素 0.1g 最终pH 7.2±0.2 |
||||||||||||||||||||||||||||||||||||||||||||||||||||||||||||||||||||||||||||||||||||||||||||||||||||||||||||||||||||||||||||||||||||
| 原理 | 蛋白胨提供碳源和氮源;葡萄糖提供能源;磷酸二氢钾为缓冲剂;硫酸镁提供必须的微量元素;琼脂是培养基的凝固剂;氯霉素可抑制细菌的生长;孟加拉红作为选择性抑菌剂可抑制细菌的生长,并可减缓某些霉菌因生长过快而导致菌落漫延生长。 | ||||||||||||||||||||||||||||||||||||||||||||||||||||||||||||||||||||||||||||||||||||||||||||||||||||||||||||||||||||||||||||||||||||
| 用法 | 1、称取孟加拉红(虎红)琼脂31.6g,加入蒸馏水或去离子水1 L,搅拌加热煮沸至完全溶解,分装三角瓶,121℃高压灭菌20min。 2、无菌操作称取检样25克(或25mL),放入含有225mL灭菌水的玻璃三角瓶中,振摇30min,即为1:10稀释液,依次做1:100、1:1000……稀释。 3、根据对样品污染情况的估计,选择2—3个合适的稀释度,分别在做10倍稀释的同时,吸取1mL稀释液于灭菌平皿中,每个稀释度做2个平皿。 4、将凉至45℃左右的培养基注入平皿中,待琼脂凝固后,倒置于25—28℃温箱中培养。 5、3d后开始观察结果,共培养观察5d。 6、计算方法:通常选择菌落数在10—150之间的平皿进行计数(如食品卫生国家标准),也有选用5—50个之间的平皿进行计数(化妆品卫生规范),同稀释度的2个平皿菌落平均数乘以稀释倍数,即为每克(或每mL)检样中所含霉菌和酵母菌数。 |
||||||||||||||||||||||||||||||||||||||||||||||||||||||||||||||||||||||||||||||||||||||||||||||||||||||||||||||||||||||||||||||||||||
| 质量控制 | 孟加拉红(虎红)琼脂倾注平皿后呈玫瑰红色,下列菌株接种后20—25℃培养72h生长情况如下表:![]() |
||||||||||||||||||||||||||||||||||||||||||||||||||||||||||||||||||||||||||||||||||||||||||||||||||||||||||||||||||||||||||||||||||||
| 相关培养基 |
|
||||||||||||||||||||||||||||||||||||||||||||||||||||||||||||||||||||||||||||||||||||||||||||||||||||||||||||||||||||||||||||||||||||
| 图片 | ![]() |
||||||||||||||||||||||||||||||||||||||||||||||||||||||||||||||||||||||||||||||||||||||||||||||||||||||||||||||||||||||||||||||||||||
| 发布时间 | 2019-11-04 |